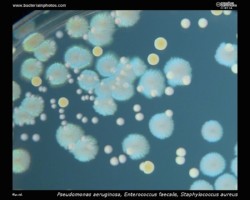
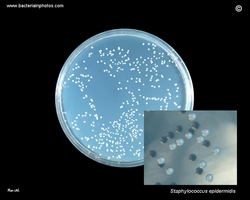

- Gram stain: Gram-positive
- Microscopic appearance: cocci in grape-like clusters
- Oxygen relationship: facultatively anaerobic bacteria
- Motility: nonmotile
- Catalase test: catalase-positive
- Oxidase test: negative*
- Spores: non-spore forming
* Some species (non-human isolates) are positive
Members of the genus Staphylococcus are Gram-positive cocci that occur singly, in pairs, tetrads, and irregular grape-like clusters. Like all medically important cocci, they are nonflagellate, nonmotile, and non-spore forming. Staphylococci grow best aerobically, but are facultatively anaerobic. In contrast to streptococci, staphylococci produce catalase.
Staphylococcus aureus
- Beta-hemolysis on media with blood (sheep, horse)
- Yellow-pigmented colonies
- NaCl tolerant (7.5%), mannitol fermentation
- Production of coagulase (free and cell-bound coagulase)
- Lithium chloride and potassium tellurite tolerant
- Lecithinase production and lipase activity
- Biofilm formation
- Often multidrug resistant (MRSA, VRSA)
Staphylococcus aureus is a commensal and a pathogen. The anterior nares are the major site of colonization in humans. It is estimated that about 20-30% of individuals are persistent carriers of S. aureus.
The most common S.aureus infections include impetigo, boils, carbuncles, abscesses, and infected wounds. S. aureus is one of the main causes of hospital- and community-acquired infections which
can result in serious consequences. Nosocomial S. aureus infections typically affect skin, soft tissues and lower respiratory tracts. S. aureus can be a cause of central
venous catheter-associated bacteremia and ventilator- assisted pneumonia. It can also cause serious deep-seated infections, such as endocarditis and osteomyelitis. In rare cases, community acquired S. aureus may result in bacteremia, meningitis, pneumonia, or necrotizing fasciitis.
Staphylococcus aureus has been confirmed to be the causative agent of many cases of severe food poisoning.
Transmission: Usually by contaminated hands, contact with infected or colonized site.
On a rich medium, S. aureus forms medium size yellow pigmented ("golden") colonies. On sheep or horse blood agar plates, colonies
of S. aureus often cause beta-hemolysis. The golden pigmentation of colonies is caused by the presence of carotenoids and has been reported to be a virulence factor protecting the pathogen against oxidants produced by the immune system.
What is MRSA?
MRSA (Methicillin-resistant Staphylococcus aureus) is any strain of S.aureus that has developed resistance to beta-lactam antibiotics , which include the penicillins and the cephalosporins.

Staphylococcus epidermidis
- Nonhemolytic colonies on media with blood (sheep, horse)
- White or creamy colonies
- NaCl tolerant (7.5%), doesn't ferment mannitol
- Doesn't produce coagulase
- Lithium chloride and potassium tellurite tolerant
- Lecithinase and lipase negative
- Biofilm formation
- Often multidrug resistant
The coagulase-negative staphylococci are widely distributed over the surfaces of the human body, where they constitute the majority of the commensal bacterial microflora. Staphylococcus epidermidis is an almost universal inhabitant of the skin. It can cause infection, however, when local systemic defenses are compromised.
S.epidermidis is the most frequent coagulase-negative Staphylococcus isolated from bloodstream infections . Its prevalence is associated with its tendency to colonize central venous catheters and other implanted medical devices , which relies on its ability to develop bacterial biofilm.
Coagulase-negative staphylococci are the third most common cause of infective endocarditis after S. aureus and viridans streptococci and the second most common cause of prosthetic valve associated infective endocarditis and other intracardiac devices after S. aureus [1].

[1] Murdoch DR, Corey GR, Hoen B, et al. Clinical presentation, etiology, and outcome of infective endocarditis in the 21st century: the International Collaboration on Endocarditis- Prospective Cohort Study. Arch Intern Med. 2009;169:463-73.